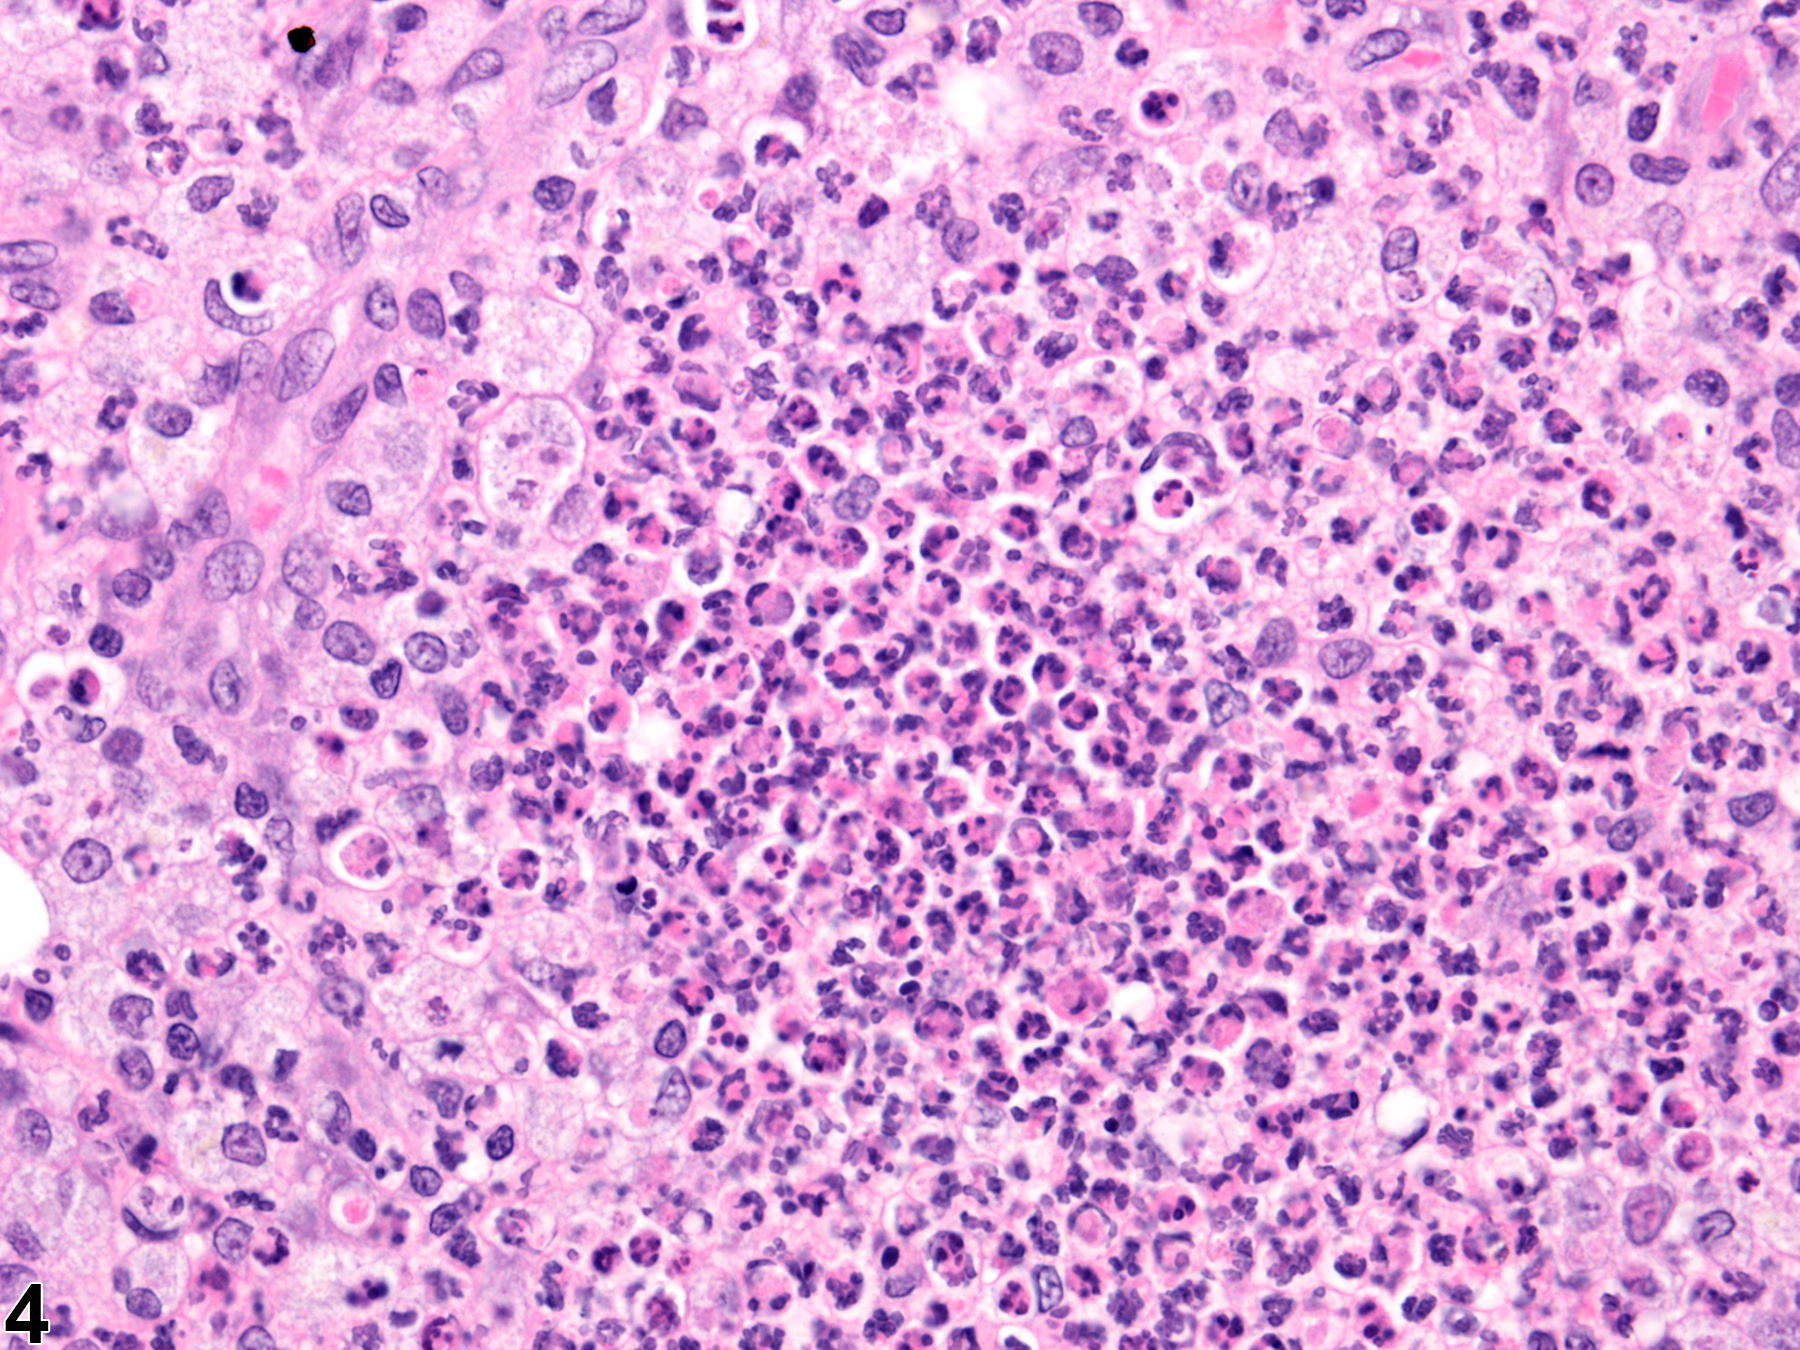

Integumentary System
Mammary Gland - Inflammation
Narrative
Comment:
Focal inflammatory infiltrates of comparatively pure populations of lymphocytes, plasma cells, neutrophils, or macrophages, either alone or mixed cell populations, can be observed in the lamina propria of the mammary gland lobule and associated tissues. Care should be taken not to confuse inflammatory cell infiltrates with a tangential section of the mammary lymph node. Inflammation of the mammary gland in rodent species is uncommon. When observed, it may be nonspecific or it can be related to trauma, or an incidental bacterial infection associated with duct dilatation, or it can be an extension from inflammation involving the overlying skin. Secondary inflammation of the mammary gland can be associated with other findings, such as degeneration or neoplasia. Mammary gland inflammation can also result from experimental manipulations, such as implantation of foreign materials.
Acute inflammation (Figure 1 and Figure 2) in the mammary gland is characterized by infiltration of neutrophils, which may be accompanied by eosinophils and, to a lesser extent, macrophages, mast cells, lymphocytes, and plasma cells. These cellular infiltrates are generally accompanied by vascular congestion; edema; the accumulation of serous, mucous, or fibrinous exudates; and sloughed epithelial cells in tubular and/or alveolar lumina. Suppurative inflammation (Figure 3 and Figure 4) of the mammary gland is characterized by discrete pockets of degenerate neutrophils and cellular debris. Evidence of chronicity, such as fibrosis and lymphoplasmacytic infiltrates, may also surround these pockets. Chronic inflammation of the mammary gland is characterized by the presence of mononuclear cells (lymphocytes, plasma cells, and macrophages) and may be accompanied by epithelial cell regeneration, hyperplasia and/or metaplasia, and fibrosis. Chronic active inflammation of the mammary gland is characterized by the coexistence of elements of chronic inflammation (lymphocytes, macrophages, regeneration, hyperplasia, and fibrosis) and superimposed acute inflammation (neutrophilic and/or eosinophilic). Granulomatous inflammation is characterized by an accumulation of plump macrophages (epithelioid cells) organized in interlacing bundles, with variable numbers of multinucleated giant cells, lymphocytes, plasma cells, or neutrophils and may be accompanied by fibrosis epithelial cell regeneration, hyperplasia, and/or metaplasia. Granulomatous inflammation is commonly seen in rats associated with rupture of dilated ducts. Other etiologic agents may be present and induce inflammatory changes (e.g., fungi, foreign bodies, etc.). All forms of inflammation may be accompanied by associated lesions, including edema (though this is more commonly associated with acute inflammation), epithelial hyperplasia, neovascularization, or hemorrhage with or without hemosiderin-containing macrophages.
Acute inflammation (Figure 1 and Figure 2) in the mammary gland is characterized by infiltration of neutrophils, which may be accompanied by eosinophils and, to a lesser extent, macrophages, mast cells, lymphocytes, and plasma cells. These cellular infiltrates are generally accompanied by vascular congestion; edema; the accumulation of serous, mucous, or fibrinous exudates; and sloughed epithelial cells in tubular and/or alveolar lumina. Suppurative inflammation (Figure 3 and Figure 4) of the mammary gland is characterized by discrete pockets of degenerate neutrophils and cellular debris. Evidence of chronicity, such as fibrosis and lymphoplasmacytic infiltrates, may also surround these pockets. Chronic inflammation of the mammary gland is characterized by the presence of mononuclear cells (lymphocytes, plasma cells, and macrophages) and may be accompanied by epithelial cell regeneration, hyperplasia and/or metaplasia, and fibrosis. Chronic active inflammation of the mammary gland is characterized by the coexistence of elements of chronic inflammation (lymphocytes, macrophages, regeneration, hyperplasia, and fibrosis) and superimposed acute inflammation (neutrophilic and/or eosinophilic). Granulomatous inflammation is characterized by an accumulation of plump macrophages (epithelioid cells) organized in interlacing bundles, with variable numbers of multinucleated giant cells, lymphocytes, plasma cells, or neutrophils and may be accompanied by fibrosis epithelial cell regeneration, hyperplasia, and/or metaplasia. Granulomatous inflammation is commonly seen in rats associated with rupture of dilated ducts. Other etiologic agents may be present and induce inflammatory changes (e.g., fungi, foreign bodies, etc.). All forms of inflammation may be accompanied by associated lesions, including edema (though this is more commonly associated with acute inflammation), epithelial hyperplasia, neovascularization, or hemorrhage with or without hemosiderin-containing macrophages.
Recommendations:
If inflammation of the mammary gland occurs as a primary lesion, it should be diagnosed and assigned a severity grade. An appropriate modifier should be included in the diagnosis to indicate the type of inflammation present. The modifiers to be used in NTP or DTT studies should be limited to acute, suppurative, chronic, chronic-active, or granulomatous. Abscesses should be diagnosed as suppurative inflammation. If another modifier, such as eosinophilic, is desirable, they may be used, but justification must be included in the pathology narrative. Inflammation occurring secondary to other lesions (such as duct dilatation or neoplasia) should not be diagnosed separately unless warranted by severity but should be described in the pathology narrative. Lesions that are considered to be secondary to the inflammation, such as hemorrhage or necrosis, should not be diagnosed separately unless warranted by severity.
References:
| Devor DE, Waalkes MP, Goering P, Rehm S. 1993. Development of an animal model for testing human breast implantation materials. Toxicol Pathol 21(3):261-73. |
| Greaves P. 2007. Mammary gland. Histopathology of preclinical toxicity studies. Interpretation and relevance in drug safety evaluation, 3rd ed. Academic Press pp. 68-98. |
| Rehm S, Liebalt AG. Nonneoplastic and neoplastic lesions of the mammary gland. In: Mohr U, Dungworth DL, Ward J, Capen CC, Carlton WW, Sundberg JP (eds.). 1996. Pathobiology of the aging mouse, Vol. 2. International Life Sciences Institute Press pp. 381-398. |
| Tucker MJ. 1997. The integumentary system and mammary glands. Diseases of the Wistar rat. CRC Press pp. 23-36. |
Van Zwieten MJ, HogenEsch H, Majka JA, Boorman GA. Nonneoplastic and neoplastic lesions of the mammary gland. In: Mohr U, Dungworth DL, Capen CC (eds.). 1994. Pathobiology of the aging rat, Vol. 2. International Life Sciences Press pp. 459-474.
 Mammary gland - Inflammation, chronic active in a female B6C3F1/N mouse from a chronic study. Mammary gland inflammation (featuring infiltrates consisting mainly of neutrophils) is located primarily in the stroma between alveoli.
Mammary gland - Inflammation, chronic active in a female B6C3F1/N mouse from a chronic study. Mammary gland inflammation (featuring infiltrates consisting mainly of neutrophils) is located primarily in the stroma between alveoli.